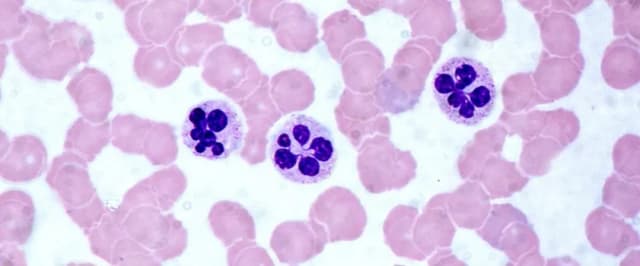
Podwyższony poziom leukocytów we krwi – co to oznacza i jakie są przyczyny? Podwyższony poziom leukocytów we krwi – co to oznacza i jakie są przyczyny?

Jaki lek na zapalenie żołądka? poznaj skuteczne opcje leczenia i porady
Szukasz skutecznych leków na zapalenie żołądka? Sprawdź, jakie są najlepsze opcje leczenia i jak złagodzić objawy.
Jaki lek na zapalenie żołądka? poznaj skuteczne opcje leczenia i porady
Szukasz skutecznych leków na zapalenie żołądka? Sprawdź, jakie są najlepsze opcje leczenia i jak złagodzić objawy.
Czy ceny leków na receptę są wszędzie takie same? Różnice, które zaskakują
Dowiedz się, czy ceny leków na receptę są wszędzie takie same. Poznaj różnice w cenach leków w różnych krajach oraz wpływ refundacji na ich koszty.
Ile można trzymać mocz w lodówce? Kluczowe informacje dla Twojego badania
Dowiedz się, ile można trzymać mocz do badania w lodówce. Poznaj zasady przechowywania moczu, aby uzyskać wiarygodne wyniki w laboratorium.
Na co jest lek Cipronex? Zastosowanie, działanie i skutki uboczne.
Dowiedz się, na co jest lek Cipronex, jakie ma zastosowanie, działanie cyprofloksacyny oraz potencjalne skutki uboczne i wskazania do stosowania.
Jakie badania pomagają w diagnozowaniu problemów z pamięcią?
Zastanawiasz się, jakie badania pomagają w diagnozowaniu problemów z pamięcią? Sprawdź, jakie testy pamięciowe i przyczyny wpływają na twoją pamięć.
Leki na erekcję – co to jest i jak działają? Poznaj szczegóły!
Poznaj leki na erekcję – co to jest i jak działają? Sprawdź, jak inhibitory PDE5 mogą pomóc w zaburzeniach erekcji i poprawić Twoje życie seksualne.
Jakie leki po covidzie na wzmocnienie? Kluczowe suplementy i dieta dla zdrowia
Poznaj, jakie leki po covidzie na wzmocnienie mogą pomóc w regeneracji organizmu. Dowiedz się o suplementach, diecie i preparatach wspierających zdrowie po COVID-19.
Jakie leki na nadciśnienie wycofane i dlaczego warto to wiedzieć
Dowiedz się, jakie leki na nadciśnienie wycofane z obrotu oraz jakie są powody ich usunięcia. Sprawdź alternatywy i zadbaj o swoje zdrowie.
Podwyższony poziom płytek krwi: poznaj przyczyny i objawy nadpłytkowości
Poznaj podwyższony poziom płytek krwi, jego przyczyny oraz objawy nadpłytkowości. Dowiedz się, co powoduje zwiększoną liczbę płytek krwi i jak to leczyć.
Jakie leki na alergie skórne skutecznie łagodzą objawy i przynoszą ulgę?
Poznaj, jakie leki na alergie skórne skutecznie łagodzą objawy, takie jak świąd i wysypki. Sprawdź dostępne preparaty i ich działanie.